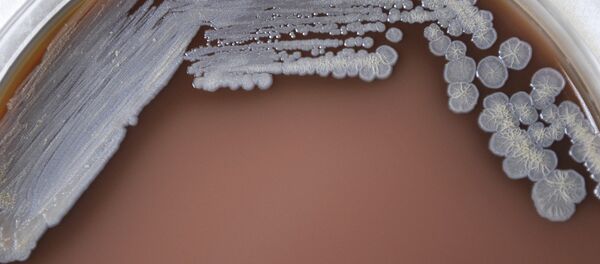
Burkholderia pseudomallei - Sputnik International

The US Department of Agriculture (USDA) examiner had antibodies in her blood tests, indicating she had been exposed to the bacteria, Burkholderia pseudomallei. She is currently recovering.
The bacteria is spread through direct contact with contaminated soil and water, and could cause fatal infectious disease to animals and humans.
Investigators say, the bacteria was accidentally leaked from the Tulane National Primate Research Center in Louisiana, where researchers were using rodents to test a vaccine against it.
But several rhesus macaques monkeys that were securely contained in a lab located in another building on the same campus, somehow contracted the bacterial infection.
Two were living in large outdoor cages when discovered to have it in November and had to be euthanized. But Tulane officials said that they may have been ill from something else before catching the bacteria.

Several rhesus macaques monkeys that were securely contained in a lab located in another building on the same campus, somehow contracted the bacterial infection.
© Flickr / yasa_
The two other monkeys that tested positive never showed any signs of illness.
The fifth monkey, IL88, was admitted to the veterinary hospital on Dec. 30 for treatment of injuries and was cared for in the same room as the four others, according to an email sent by the Centers for Disease Control and Prevention (CDC) to federal and state investigators.
By Feb. 23, the monkey had developed two ulcers on its abdomen. The ulcers were cultured and the animal had to be euthanized.
Federal and state investigators have been conducting a thorough investigation, trying to determine how the bacteria was leaked, for several weeks now. They have yet to find out the cause of the release and the extent of contamination.
The center has halted the research with the bacteria since the investigation is in process.

Investigators say, the bacteria was accidentally leaked from the Tulane National Primate Research Center in Louisiana, where researchers were using rodents to test a vaccine against it.
© Flickr / Tulane Public Relations
Rutgers University biosafety expert Richard Ebright described the release as worrying, predicting human error to be the potential cause.
“The fact that they can't identify how this release occurred is very concerning,” he told USA Today.
“Human error is always the first explanation you should consider for a laboratory accident. The easiest way to transfer something from one place where it's supposed to be, to another where it isn't supposed to be is by a worker moving from one place to the other.”
Although the university has been taking extreme measures to contain the spreading, the CDC denied any public health threat.
The bacteria can cause melioidosis, a potentially fatal disease for humans and animals, with symptoms like fever, headache and join pain.
Louisiana state officials have expressed concerns that the bacteria has contaminated the environment outside the facility, since it can live and grow in soil and water.
This is the latest in a series of significant accident releases that have taken place across the US.
More than 1,100 laboratory incidents involving bacteria, viruses and toxins that pose significant or bioterror risks to people and agriculture were reported to federal regulators during 2008 through 2012, according to the CDC.
More than half these incidents were serious enough that lab workers received medical evaluations or treatment, according to the reports. In five incidents, investigations confirmed that laboratory workers had been infected or sickened. All have recovered.